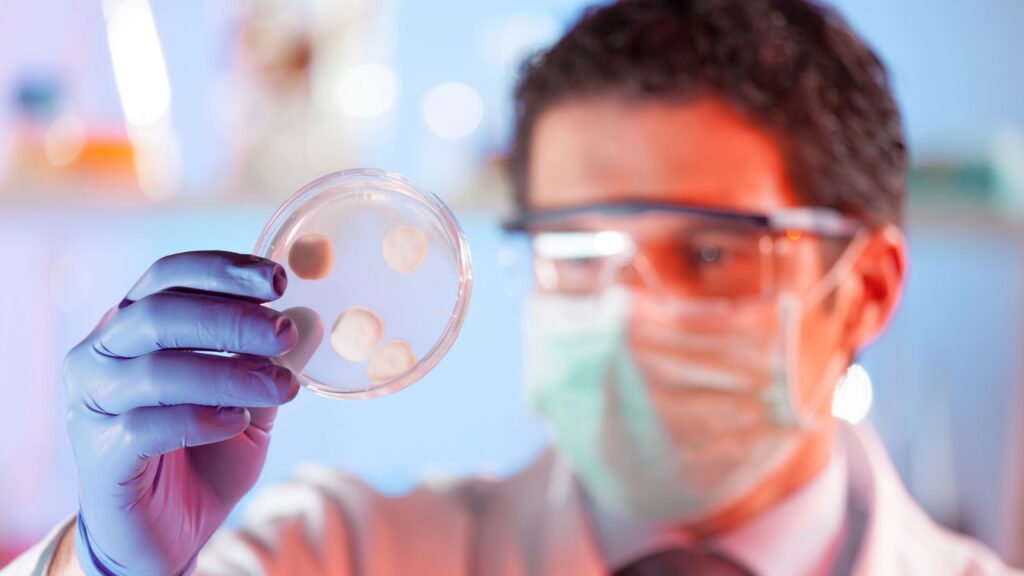

O Fluconazol é amplamente empregado no tratamento de infecções fúngicas que afetam diversas partes do corpo, como a vagina, boca, garganta, pulmões, bexiga ou até mesmo o sangue. Pertencente à classe dos triazóis, este medicamento atua inibindo o crescimento dos fungos, sendo eficaz contra uma variedade de infecções.
Este antifúngico é comumente prescrito para condições como candidíase vaginal, tanto aguda quanto recorrente, balanite, dermatomicoses, criptococoses, candidíase sistêmica e infecções mucosas. Além disso, o Fluconazol pode ser utilizado preventivamente em pacientes com alto risco de infecções fúngicas, especialmente aqueles com histórico de câncer, submetidos a transplantes ou portadores de HIV.
Quais as formas de administração e dosagem?
Disponível apenas com receita médica, o Fluconazol pode ser encontrado em formas variadas, incluindo comprimidos, suspensão oral e injeções. É crucial que o paciente siga rigorosamente as instruções médicas quanto à dosagem e duração do tratamento para garantir a eficácia do medicamento e reduzir o risco de efeitos adversos.
O médico determinará a forma de administração mais adequada e a dosagem específica com base na gravidade da infecção e no perfil individual do paciente, considerando fatores como peso, idade e condição médica subjacente.
Efeitos colaterais: quais são os riscos do Fluconazol?
O uso do Fluconazol é geralmente seguro, mas pode ocasionar alguns efeitos colaterais leves. Entre os sintomas relatados estão dor de cabeça, diarreia, náusea, tontura, dor de estômago e alterações na percepção do sabor.
Caso surjam sintomas mais graves, como reações cutâneas, lesões hepáticas ou sinais de insuficiência adrenal, é fundamental interromper o uso do medicamento e buscar orientação médica imediatamente. Estes eventos são raros, mas requerem atenção médica imediata.
Existem contraindicações e precauções?
O Fluconazol é contraindicado para indivíduos alérgicos a antifúngicos azólicos ou a qualquer componente de sua formulação. Adicionalmente, deve ser evitado por pacientes em tratamento com drogas como eritromicina, pimozida e quinidina, devido ao risco de interações medicamentosas potencialmente graves.
Antes de iniciar o tratamento, o médico deve ser informado sobre qualquer condição médica existente, incluindo problemas hepáticos, renais, cardíacos ou níveis baixos de potássio no sangue. Também é importante informar se a paciente está grávida, amamentando ou planejando uma gravidez.
Questões frequentes sobre o Fluconazol
Como o Fluconazol desempenha seu papel no tratamento antifúngico? O Fluconazol inibe uma enzima essencial para a formação de uma membrana celular fúngica funcional, comprometendo a viabilidade do fungo.
Quando o uso do Fluconazol deve ser interrompido? Devem-se observar reações adversas e, em casos de sintomas graves ou inesperados, é recomendado suspender o uso do medicamento e buscar aconselhamento médico.
Entre em contato:
Dra. Anna Luísa Barbosa Fernandes
CRM-GO 33.271









